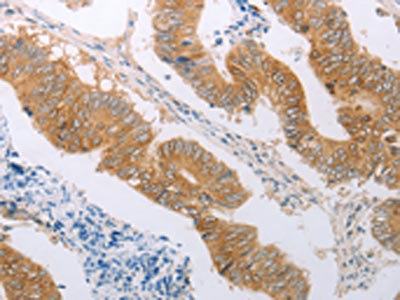

PDK4 Antibody
-
中文名稱:PDK4兔多克隆抗體
-
貨號:CSB-PA642637
-
規格:¥1100
-
圖片:
-
The image on the left is immunohistochemistry of paraffin-embedded Human colon cancer tissue using CSB-PA642637(PDK4 Antibody) at dilution 1/50, on the right is treated with synthetic peptide. (Original magnification: ×200)
-
The image on the left is immunohistochemistry of paraffin-embedded Human breast cancer tissue using CSB-PA642637(PDK4 Antibody) at dilution 1/50, on the right is treated with synthetic peptide. (Original magnification: ×200)
-
Gel: 10%SDS-PAGE, Lysate: 60 μg, Lane: Mouse pancreas tissue, Primary antibody: CSB-PA642637(PDK4 Antibody) at dilution 1/700, Secondary antibody: Goat anti rabbit IgG at 1/8000 dilution, Exposure time: 2 minutes
-
-
其他:
產品詳情
-
Uniprot No.:
-
基因名:PDK4
-
別名:[Pyruvate dehydrogenase [lipoamide]] kinase isozyme 4 antibody; FLJ40832 antibody; mitochondrial antibody; Pdk4 antibody; PDK4_HUMAN antibody; Pyruvate dehydrogenase [lipoamide] kinase isozyme 4 mitochondrial antibody; Pyruvate dehydrogenase kinase 4 antibody; Pyruvate dehydrogenase kinase isoenzyme 4 antibody; Pyruvate dehydrogenase kinase isoform 4 antibody; Pyruvate dehydrogenase kinase isozyme 4 antibody; Pyruvate dehydrogenase kinase isozyme 4 mitochondrial antibody
-
宿主:Rabbit
-
反應種屬:Human,Mouse,Rat
-
免疫原:Synthetic peptide of Human PDK4
-
免疫原種屬:Homo sapiens (Human)
-
標記方式:Non-conjugated
-
抗體亞型:IgG
-
純化方式:Antigen affinity purification
-
濃度:It differs from different batches. Please contact us to confirm it.
-
保存緩沖液:-20°C, pH7.4 PBS, 0.05% NaN3, 40% Glycerol
-
產品提供形式:Liquid
-
應用范圍:ELISA,WB,IHC
-
推薦稀釋比:
Application Recommended Dilution ELISA 1:1000-1:5000 WB 1:500-1:2000 IHC 1:50-1:200 -
Protocols:
-
儲存條件:Upon receipt, store at -20°C or -80°C. Avoid repeated freeze.
-
貨期:Basically, we can dispatch the products out in 1-3 working days after receiving your orders. Delivery time maybe differs from different purchasing way or location, please kindly consult your local distributors for specific delivery time.
-
用途:For Research Use Only. Not for use in diagnostic or therapeutic procedures.
相關產品
靶點詳情
-
功能:Kinase that plays a key role in regulation of glucose and fatty acid metabolism and homeostasis via phosphorylation of the pyruvate dehydrogenase subunits PDHA1 and PDHA2. This inhibits pyruvate dehydrogenase activity, and thereby regulates metabolite flux through the tricarboxylic acid cycle, down-regulates aerobic respiration and inhibits the formation of acetyl-coenzyme A from pyruvate. Inhibition of pyruvate dehydrogenase decreases glucose utilization and increases fat metabolism in response to prolonged fasting and starvation. Plays an important role in maintaining normal blood glucose levels under starvation, and is involved in the insulin signaling cascade. Via its regulation of pyruvate dehydrogenase activity, plays an important role in maintaining normal blood pH and in preventing the accumulation of ketone bodies under starvation. In the fed state, mediates cellular responses to glucose levels and to a high-fat diet. Regulates both fatty acid oxidation and de novo fatty acid biosynthesis. Plays a role in the generation of reactive oxygen species. Protects detached epithelial cells against anoikis. Plays a role in cell proliferation via its role in regulating carbohydrate and fatty acid metabolism.
-
基因功能參考文獻:
- Results show that PDK4-specific 5'UTR DNA methylation is positively associated with eicosapentaenoic and arachidonic acid in adult males. PMID: 27181711
- it was found that low expression of FAM210B was significantly correlated with decreased survival and enhanced metastasis in vivo and in vitro, and the loss of FAM210B led to an increased mitochondrial respiratory capacity and reduced glycolysis through the downregulation of pyruvate dehydrogenase kinase 4 (PDK4). PMID: 28594398
- In conclusion, our data indicated that PDK4 potentially contributes to the hepatic steatosis in NASH via regulating several signaling pathway and PDK4 may be a new therapeutic strategy against NAFLD. PMID: 29128353
- Low PDK4 expression is associated with lung tumorigenesis. PMID: 27641336
- Increased PDK4 expression is associated with colon cancer. PMID: 28208156
- We found that PDK4 gene and protein expression was significantly elevated in pulmonary arterial hypertension pericytes and correlated with reduced mitochondrial metabolism, higher rates of glycolysis, and hyperproliferation PMID: 27456128
- Inhibition of CK2 increased the expression of metabolic regulators, PDK4 and AMPK along with the key cellular energy sensor CREB. PMID: 27001465
- These findings indicate that the TGFbeta/PDK4 signaling axis plays an important role in the response of colorectal cancer to chemotherapy. PMID: 27330076
- inhibition of PDK4 activity in Hepatocellular carcinoma cells increased cyclin E1, cyclin A2, and E2F1 proteins. PMID: 28003426
- FXR may promote the proliferation of tumor cells and the hepatocytes in the process of liver regeneration by activating the PDK4-mediated metabolic reprogramming to generate glycolytic intermediates essential for rapid biomass generation, establishing a mechanistic link between cell proliferation and metabolic switch. PMID: 26728993
- Combined speed endurance and endurance exercise amplify the exercise-induced PGC-1alpha and PDK4 mRNA response in trained human muscle. PMID: 27456910
- High PDK4 expression is associated with hepatocellular cancer. PMID: 26506419
- upregulation of PDK4 promotes vascular calcification by increasing osteogenic markers with no adverse effect on bone formation, demonstrating that PDK4 is a therapeutic target for vascular calcification. PMID: 26560812
- Fatty acids induce the expression of PDK4 mRNA, which was increased in myotubes cultured from obese and T2DM donors. PMID: 25311062
- Swiss PDB Viewer identifies NFkappaB subunit p100/p49 as a potential interacting partner for PDK4. Relationship between PDK4 and apoptosis is suggested. PMID: 25794976
- ZBTB2 may increase cell proliferation by reprogramming glucose metabolic pathways to favor glycolysis by upregulating PDK4 expression via repression of RelA/p65 expression PMID: 25609694
- Methylation increased in PDK4, IL1 B, IL6, and TNF promoters 12 months after gastric bypass. PMID: 24837562
- PDK4 promotes tumorigenesis through activation of the CREB-RHEB-mTORC1 signaling cascade. PMID: 25164809
- Data show that the orphan nuclear receptor estrogen related receptor gamma (ERRgamma) plays a critical role in hypoxia-mediated activation of pyruvate dehydrogenase kinase 4 (PDK4) gene expression. PMID: 23050013
- mRNA of PGC-1alpha and PDK4 increases markedly in both type I and type II skeletal muscle after either continuous or interval exercise PMID: 21883960
- PDK4 polymorphisms may not be associated with type 2 diabetes or metabolic syndrome. PMID: 22019269
- The present structures demonstrate the flexible and dynamic aspects of PDK4 in the open conformation and provide a basis for the development of novel inhibitors targeting the nucleotide-binding pocket of PDK4. PMID: 21904029
- PDK4 gene is downregulated in colic adenocarcinoma. PMID: 20715114
- The expression of the pyruvate dehydrogenase kinase 4 was downregulated in the failing heart. PMID: 12145475
- results support the concept that a reduced tissue availability of fatty acids consequent to a massive lipid malabsorption influences glucose metabolism acting through the regulation of pyruvate dehydrogenase kinase 4 PMID: 12582211
- mRNA levels are increased in skeletal muscle during fasting PMID: 14966024
- Expression of constitutively active PKB alpha abrogates dexamethasone stimulation of hPDK4 promoter activity. PMID: 15047604
- Gene expression regulation is affected by retinoic acid and histone acetyation (review). PMID: 15581486
- activation of FXR may suppress glycolysis and enhance oxidation of fatty acids via inactivation of the pyruvate dehydrogenase complex by increasing PDK4 expression PMID: 15721319
- retinoic acids (RA) as well as Trichostatin A (TSA), an inhibitor of histone deacetylase (HDAC), regulate PDK4 gene expression PMID: 16757381
- Accumulation of im lipids plays a more important role than impaired activation of Akt-mediated pathways in the regulation of muscle PDK4 gene expression in lipid-induced acute insulin-resistant states PMID: 17652214
- PDK4 upregulation in adipocytes participates in the hypolipidemic effect of thiazolidinediones through modulation of glyceroneogenesis PMID: 18519799
- PDK4 with bound ADP exists in equilibrium between the open and the closed conformations PMID: 18658136
顯示更多
收起更多
-
亞細胞定位:Mitochondrion matrix.
-
蛋白家族:PDK/BCKDK protein kinase family
-
組織特異性:Ubiquitous; highest levels of expression in heart and skeletal muscle.
-
數據庫鏈接:
Most popular with customers
-
-
YWHAB Recombinant Monoclonal Antibody
Applications: ELISA, WB, IHC, IF, FC
Species Reactivity: Human, Mouse, Rat
-
Phospho-YAP1 (S127) Recombinant Monoclonal Antibody
Applications: ELISA, WB, IHC
Species Reactivity: Human
-
-
-
-
-